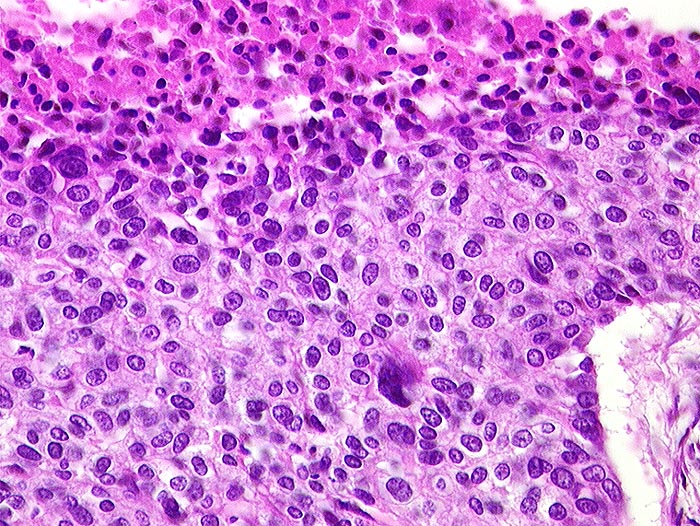

PathoPic – image database / PathoPic ID 199 - atypisches Karzinoid
de
Diagnose
atypisches Karzinoid
Diagnose Gruppe
maligner Tumor
Topographie
Lunge
Topographie Gruppe
Lunge, Mediastinum mit Thymus
Beschreibung
Solider Tumor mit Tumornekrose (obere Bildhälfte). Leichte Zellkernpleomorphie.
Zusatzbefund
4cm grosser Tumor im linken Lungenunterlappen.
Klinik
Lungentumor bekannt seit 4 Jahren.
Bilder Typ
Histologie
Alter
85
Geschlecht
männlich
Datum
Ersteintrag: 11.07.2002